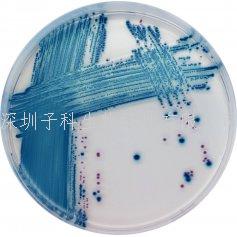
科瑪嘉產(chǎn)志賀毒素大腸桿菌STEC培養(yǎng)基

熱門關(guān)鍵詞: ELISA試劑盒 - 大鼠ELISA試劑盒- 小鼠ELISA試劑盒
全國統(tǒng)一客服熱線:
0755-28715175
熱門關(guān)鍵詞: ELISA試劑盒 - 大鼠ELISA試劑盒- 小鼠ELISA試劑盒
全國統(tǒng)一客服熱線:
0755-28715175

科瑪嘉產(chǎn)志賀毒素大腸桿菌STEC培養(yǎng)基
產(chǎn)品貨號(hào)及規(guī)格:
科瑪嘉產(chǎn)志賀毒素大腸桿菌培養(yǎng)基:
1000 ml pack ........................................ ST160
組合產(chǎn)品 = 基礎(chǔ)粉末 ST160(B) + 補(bǔ)充劑 ST160(S)
5000 ml pack ........................................ ST162
組合產(chǎn)品=基礎(chǔ)粉末 ST162(B) + 補(bǔ)充劑 ST162(S)
詳細(xì)產(chǎn)品價(jià)格及報(bào)價(jià)請(qǐng)咨詢深圳子科生物在線客服。
用途:檢測產(chǎn)志賀毒素大腸桿菌
常見產(chǎn)志賀毒素血清型大腸桿菌→淡紫色
其他大腸桿菌→無色,藍(lán)色或被抑制
革蘭氏陽性菌→被抑制

0755-28715175/33164177

粵公網(wǎng)安備 44030902000304號(hào)